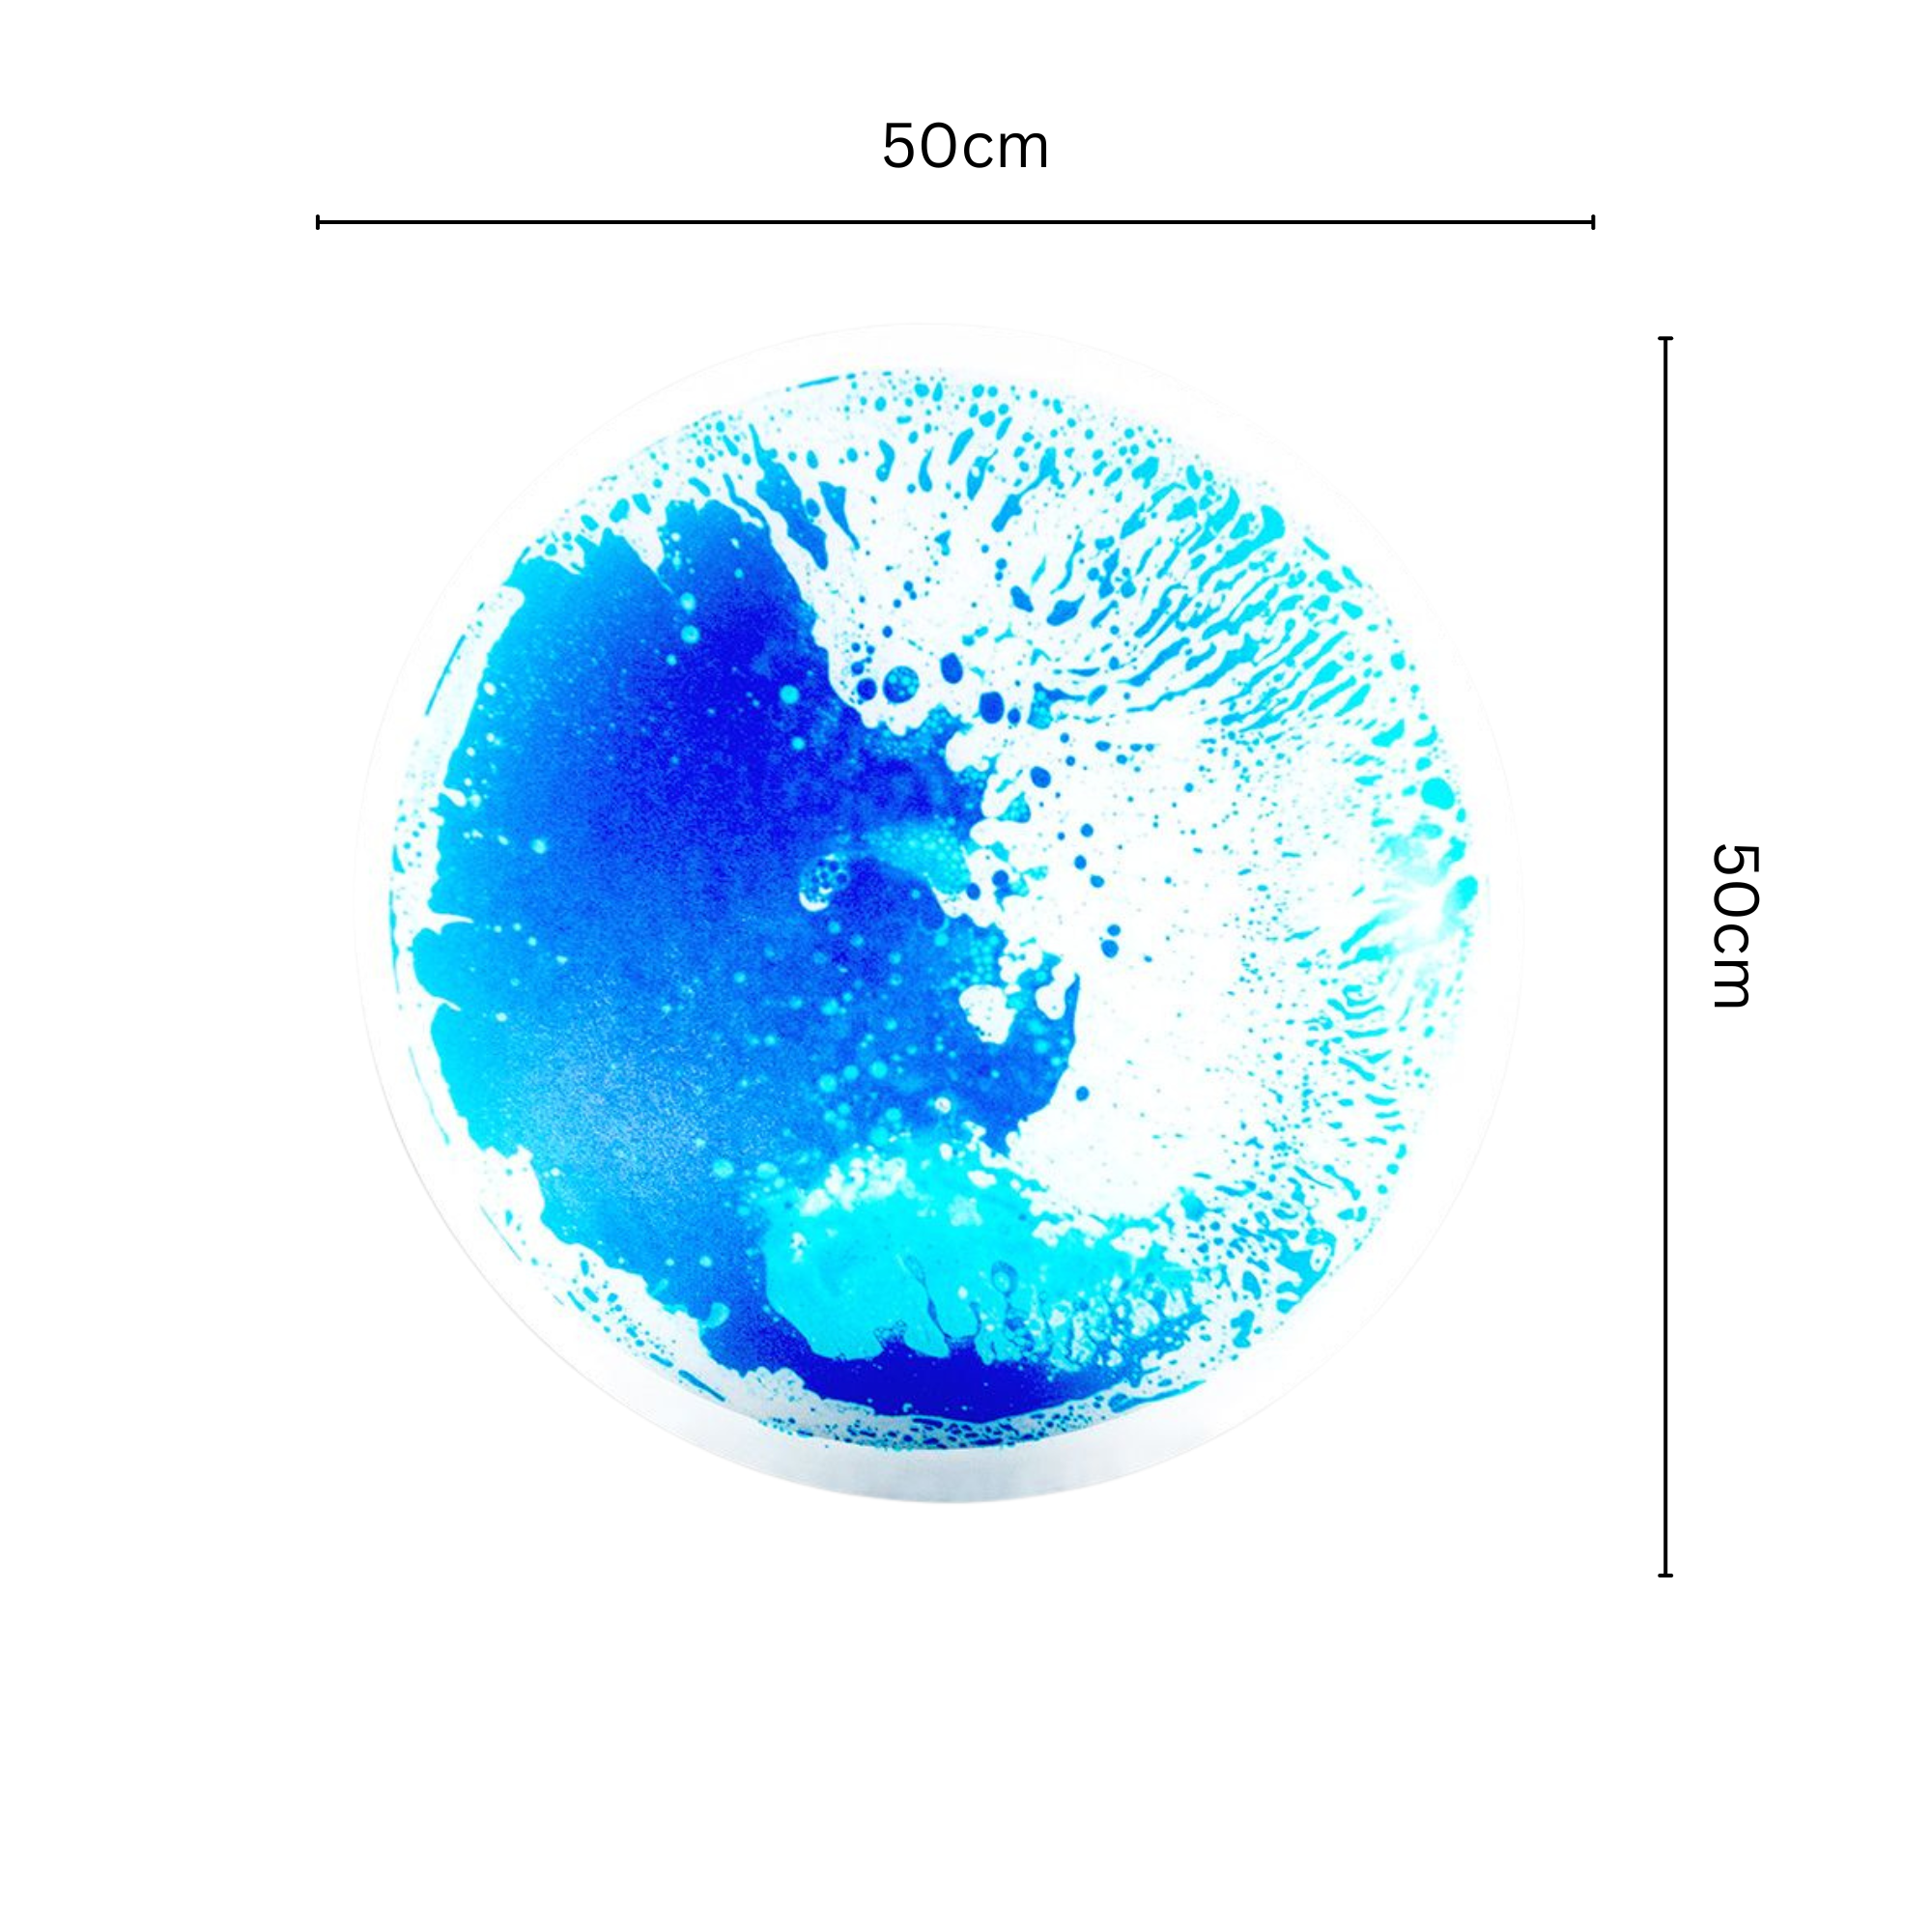

Introducing Sensory Liquid Floor Tiles - where vibrant colours meet interactive fun! Step into a world of excitement with these captivating tiles that add a splash of joy to any space.
Mesmerizing Motion
Watch as colourful liquid moves with every step, jump, or hop!
Dimensions
Each tile measures 50 x 50cm, perfect for creating your own games and activities.
Easy Setup, Instant Fun
No installation is required - simply place them anywhere for instant entertainment!
Safety First, Fun Always
Featuring an anti-slip backing for cushioning and traction, ensuring a safe play environment.
Durable Design, Long-lasting Joy
Sturdy and durable construction supports the weight of adults for endless enjoyment.
Versatile Usage
Ideal for children's playhouses, kids' rooms, dance floors, play mats, and more!
Do not expose to heat or direct sunlight, this may damage the product.
For every purchase you make, 5% will be donated directly to the Ocean Cleanup project